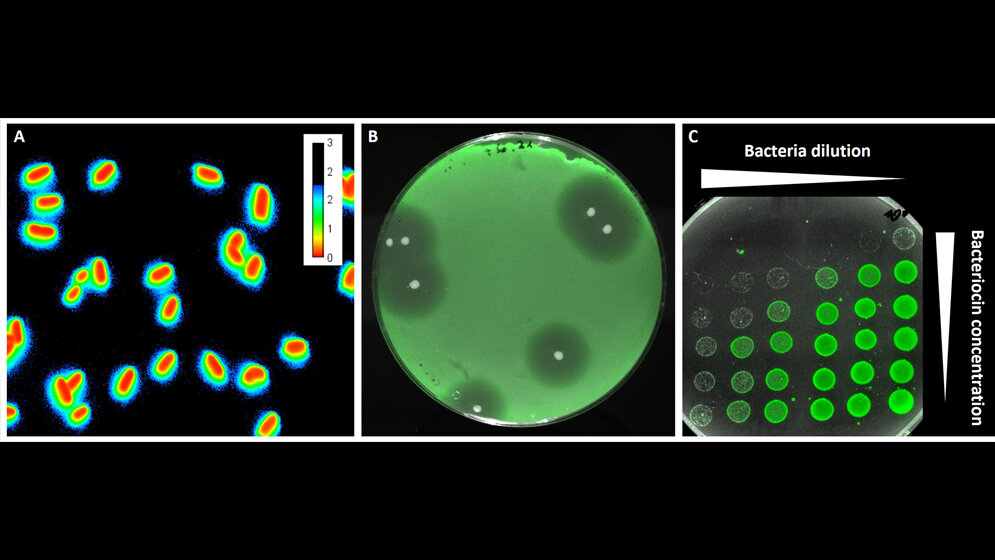
Fluoreszierende Sensorbakterien

Antibiotika-Alternative von Bodenbakterien?
Einem Forschungsteam um das Ulmer Institut für Mikrobiologie und Biotechnologie ist es gelungen, mit Hilfe gentechnisch veränderter Bodenbakterien (Corynebacterium glutamicum) antimikrobielle Wirkstoffe in Reinform herzustellen. Die so hergestellten Bacteriocine könnten als Antibiotika-Alternative zur Bekämpfung bakterieller Krankheitserreger eingesetzt werden. Und auch bei der Konservierung von Lebensmitteln könnten diese antibakteriellen Peptide wertvolle Dienste leisten.
Bacteriocine haben enormes medizinisches Potenzial
Bakterienstämme sind gerne unter sich. Um sich unliebsame Nahrungskonkurrenten vom Leib zu halten, produzieren sie antimikrobielle Substanzen, die verhindern sollen, dass sich andere Bakterienstämme in ihrer Umgebung ausbreiten. Diese sogenannten Bacteriocine werden heute schon in der Nahrungsmittelindustrie eingesetzt, um Lebensmittel zu konservieren. Bacteriocine haben aber auch enormes medizinisches Potenzial. Vor dem Hintergrund zunehmender Antibiotika-Resistenzen gelten sie als vielversprechende Alternativen zur Behandlung von Infektionen, die durch humanpathogene Bakterien ausgelöst werden.
„Für die klinische Anwendung solcher Bacteriocine braucht es neuartige, großtechnische Verfahren, die es möglich machen, die Effizienz der Produktion und die Reinheit des Stoffes massiv zu verbessern“, erklärt Professor Christian Riedel vom Institut für Mikrobiologie und Biotechnologie an der Universität Ulm.
Corynebacterium glutamicum stellt Pediocin PA-1 in Reinform her
Bisher werden Bacteriocine ausschließlich mit natürlichen Bakterien in aufwändigen Fermentationsprozessen hergestellt, bei denen komplexe und teure Nährmedien verwendet werden. So entstehen bestenfalls halbgereinigte Präparate oder Rohfermente. Für den medizinischen Einsatz – beispielsweise als Antibiotika-Ersatz – müssen die Bacteriocine aus diesen „natürlichen“ Fermentationsverfahren aufwendig gereinigt werden. Doch das ist teuer und daher wirtschaftlich uninteressant. Nun ist es Christian Riedel mit seinem Ulmer Team und anderen Fachkolleginnen und -kollegen aus Deutschland, Norwegen, Dänemark und Österreich gelungen, das Bakterium Corynebacterium glutamicum gentechnisch so zu verändern, dass es ein hochwirksames antimikrobielles Peptid (Pediocin PA-1) in Reinform herstellt. Das als Produktionswirt eingesetzte Bakterium ist ein nicht-pathogenes Bodenbakterium, das seit langem als natürlicher Produzent von Aminosäuren – beispielsweise des Geschmacksverstärkers Glutamat – bekannt ist und das heute eine wichtige Rolle als biotechnologischer Plattformorganismus spielt.
Pediocin PA-1 wirkt besonders gut gegen Listeria monocytogenes
Die Forscher haben das Bakterium mit synthetischen, zielgenau funktionalisierten Genen ausgestattet, die die Produktion des Bacteriocins bewerkstelligen. Pediocin PA-1 wirkt besonders gut gegen Listeria monocytogenes. Diese Bakterien sind in der Umwelt weit verbreitet. Werden sie allerdings über kontaminierte Nahrungsmittel wie Rohkäse aufgenommen, können sie bei Menschen eine gefährliche, mitunter sogar tödlich verlaufende Listeriose auslösen.
Corynebacterium glutamicum ist resistent
Mehrere Herausforderungen mussten die Wissenschaftlerinnen und Wissenschaftler bewältigen, um das veröffentlichte Projekt, erfolgreich zu meistern. Die größte Herausforderung: Wie bringt man Bakterien dazu, antimikrobielle Substanzen zu produzieren, die für den Produzenten potenziell toxisch sind? Und wieso hat das von C. glutamicum synthetisierte Pediocin Pa-1 keine schädigende Wirkung auf das Bodenbakterium? Das Forschungsteam um Riedel hat sich hier eine biologische Besonderheit der Mikrobe zunutze gemacht. „Corynebacterium glutamicum hat keine Rezeptoren, an denen das Bacteriocin andocken kann. Es ist daher resistent gegen dessen antibakterielle Wirkung. Ein Glücksfall für uns“, betont Dr. Oliver Goldbeck. Der Postdoc ist Wissenschaftlicher Mitarbeiter am Institut für Mikrobiologie und Biotechnologie und Erstautor der Studie. Außerdem gelang es dem Forschungsteam, die synthetische Bacteriocin-Produktion vom Labormaßstab auf einen großtechnischen Pilotmaßstab für die Industrieproduktion zu skalieren.
Fermentertechnologie billiger und ressourcenschonender machen
Eine dritte Stoßrichtung des Projektes bestand darin, die zugrundeliegende Fermentertechnologie billiger und ressourcenschonender zu machen. „Anstatt teurer Nährmedien verwenden wir Abfallstoffe aus der Holzindustrie als Substrate für die Produktion“, erklärt Riedel. Dafür haben die Kooperationspartner an der Universität des Saarlandes aus der Arbeitsgruppe von Professor Christoph Wittmann weitere genetische Veränderungen am bakteriellen Produktionswirt vorgenommen. „Dies macht es für unsere Bakterien möglich, Zucker und organische Säuren aus den Holzabfällen zu verwerten, um daraus schließlich die antimikrobiellen Peptide zu bilden“, sagt der Forscher. Den Wissenschaftlerinnen und Wissenschaftlern, die an diesem Projekt beteiligt waren, ist es also nicht nur gelungen, „nützliche“ Bakterien für sich arbeiten zu lassen, um Wirkstoffe gegen „schädliche“ Bakterien zu gewinnen. Sie haben es zugleich geschafft, ihre anspruchsvollen Nützlinge genügsamer zu machen, um diese in Zukunft preiswerter und umweltfreundlicher ernähren zu können.
Oliver Goldbeck, Dominique N. Desef, Kirill V. Ovchinnikov, et al.: Establishing recombinant production of pediocin PA-1 in Corynebacterium glutamicum. Metabolic Engineering. 2021 Sep 4; 68:34-45, DOI: 10.1016/j.ymben.2021.09.002. Online ahead of print.
Quelle: idw/Uni Ulm
Artikel teilen